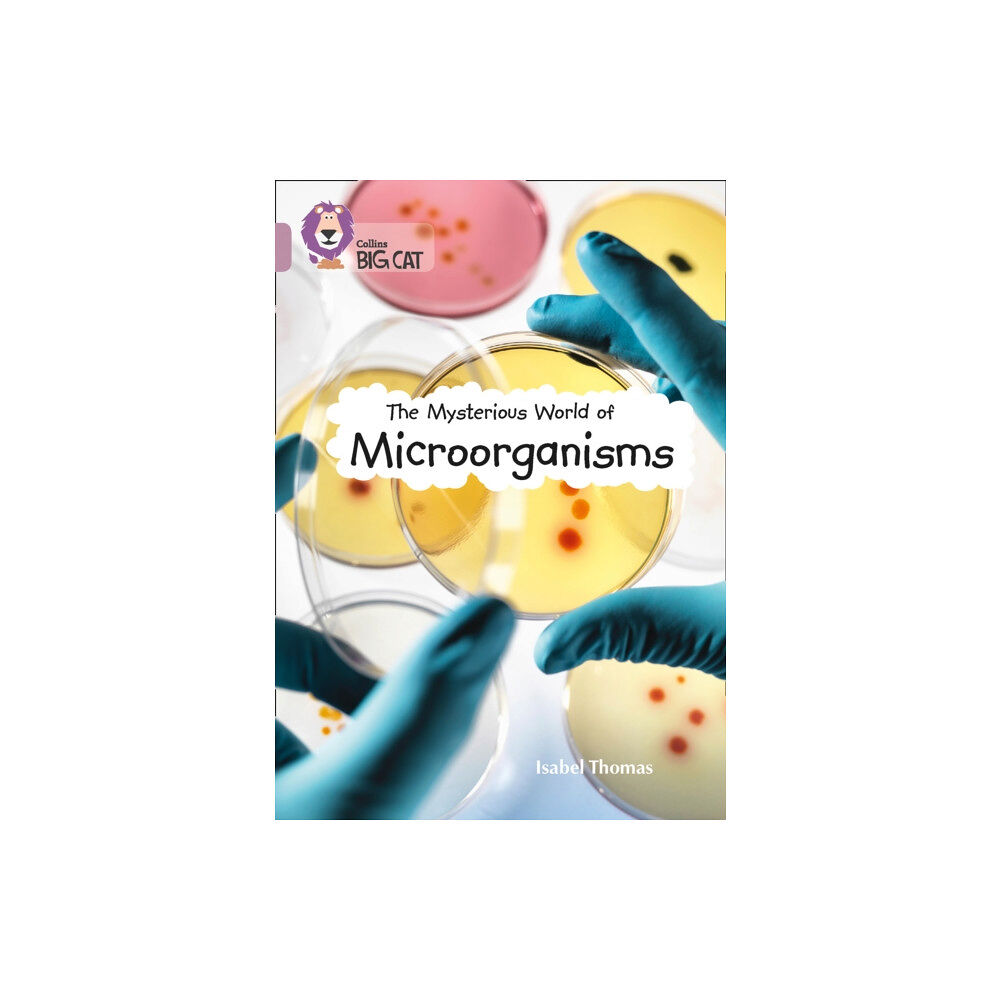
HarperCollins Publishers The Mysterious World of Microorganisms (häftad, eng)

The Mysterious World of Microorganisms (häftad, eng)
Build your child’s reading confidence at home with books at the right levelNot your average science book, this in-depth analysis of the smal...
251 kr
269 kr
inkl. moms
I lager
Skickas inom 3 - 4 vardagar
EAN: 9780008127985
Specifikation
Böcker
- Format Häftad
- Antal sidor 80
- Språk Engelska
- Utgivningsdatum 2015-09-21
- Förlag Harpercollins Publishers
- ISBN 9780008127985